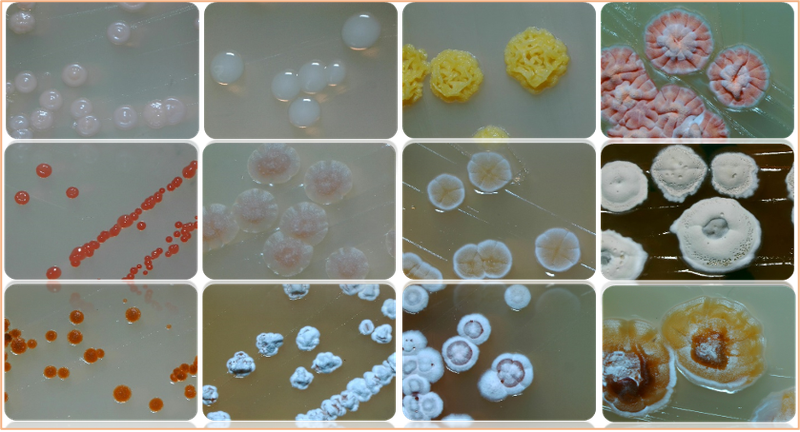
图片

万亿生物制造核心!一文汇总国内外超20家顶级菌种库
2024年12月31日
菌种改造是生物制造的关键环节,它直接决定了下游化合物的生产效率,需要投入大量的人力物力。
自2011年起,中国成为世界上每年发表微生物新种最多的国家,但实际上,我国优良菌种的自主率仍然不足5%。无论是技术水平还是知识产权,中国都较美国、日本、韩国等氨基酸强国都存在较大差距。因此,培育作为“细胞工厂”的菌种库也就成为各地产业建设的重中之重。例如广东就提出要建设中国最大的菌种库,北京将建库容10万株微生物菌种库。值得欣喜的是,目前我国已经建立起了完备的菌种资源平台,而随着专利以及产业的完善,高校和企业也开始建立起拥有自主知识产权的菌种库。本篇文章,将带大家走进这些国家级以及特色微生物资源平台。国家微生物资源平台一般称为国家菌种库,2002年开始组建,是财政部首批认定的23家国家科技基础条件平台之一。
国家菌种库依托于9个国家专业微生物菌种管理保藏中心,可以链接到农业、医学、药用、工业、兽医、普通、林业、典型培养物等微生物资源。
此外,国家微生物平台不仅对公众开放,还提供菌种识别等各类服务,是我国最权威的微生物资源平台。2019年6月,经过科技部、财政部公布,由中科院微生物研究所牵头成立了国家微生物科学数据中心。
截至目前,国家微生物科学数据中心已成为我国最重要的微生物科学数据中心,在世界上也有较大影响力。
中心累计收录了823个数据库,60亿条数据,超过6BP的存储容量。此外,数据中心还提供一站式生物信息分析平台,用户可以在线进行数据分析。CCTCC成立于1985年,隶属国家微生物资源平台,是经国家专利局、教育部批准成立的专业培养物保藏机构,1987年加入世界培养物保藏联盟(WFCC),1995年成为布达佩斯条约确认的国际培养物保藏单位(IDA)。
中国典型培养物保藏中心的保藏范围非常广,是国内查询资料或者购买细胞最权威的渠道之一。CCTCC包括细菌、放线菌、真菌、单细胞藻类、动植物病毒、噬菌体、人和动物细胞系、转基因修饰细胞系、杂交瘤、植物组织培养、植物种子、克隆载体、基因片段和基因文库等生物材料。迄今为止,已保藏有来自27个国家和地区的各类培养物40,000余株,其中专利培养物12000余株,非专利培养物中微生物菌种30,000余株。
CICC隶属于保利中轻集团中国食品发酵工业研究院,始建于1953年,1979年由科技部设立为国家级菌种保藏机构。CICC负责全国工业微生物资源的收集、保藏、共享、鉴定、评价、进出口、研究开发与交流培训。CICC保存的菌种主要用于食品发酵、生物化工、健康产业、产品质控和环境监测等领域。地址:北京市中国农业科学院农业资源与农业区划研究所ACCC是全国性的农业菌种保藏管理中心,承担全国农业微生物菌种的收集、收集、整理、鉴定与保藏等工作。目前ACCC已保藏菌种2.3万株30万份,分属于800多属、3000多种,涵盖了肥料微生物、食用菌、饲料微生物、植保微生物、农业环境微生物等。成立于1979年,隶属于中国科学院微生物研究所,是我国最主要的微生物资源保藏和共享利用机构。目前,CGMCC保存各类微生物资源超过7500种,80000余株,用于专利程序的各类生物材料23000余株,根据国家科委的要求,农业部于1980年建立了兽医微生物菌种保藏管理中心,专门从事兽医微生物菌种(包括细菌、病毒、原虫和细胞系)的收集。
截至目前,该库覆盖了兽用生物制品企业90%以上的生产、检验用菌(毒)种,每年为企业带来的直接经济效益至少可达30亿元。地址:北京市海淀区中国林业科学研究院森林生态环境与保护研究所中国林业微生物菌种保藏管理中心成立于1985年,是林业领域唯一的国家级专业菌种保藏管理中心。CFCC拥有与森林、草原、荒漠、湿地等重要陆地生态环境相关的微生物资源。
包含松茸、松露等珍贵野生大型真菌,松材线虫、杨树溃疡病菌等重要林草病原物,苏云金杆菌、昆虫病毒等生防菌,以及木腐菌、固氮菌等功能微生物资源。地点:北京市东城区中国医学科学院医药生物技术研究所
CPCC建于1958年,现保藏各类药学微生物资源56000余株。收藏菌种以放线菌和真菌为特色,具有抗病毒、抗真菌、抗耐药菌、抗结核、抗肿瘤、酶抑制剂和生物转化等多种生物活性。药学菌种资源分库提供的共享实物资源包括菌种资源、发酵液提取物及基因组DNA等。目前可共享菌株超过40000株,其中网上共享菌株10818株。国家植保微生物种质资源库是湖北省唯一一座国家植保微生物种质资源库,拥有保存着17万余株各类微生物资源。该资源库收集自全国林地、草原、荒地、河流等各类样品,将对抑制虫害起到重要作用。海洋微生物菌种保藏管理中心成立于2004年,挂靠于自然资源部第三海洋研究所。目前库藏海洋微生物3.2万株,这些菌分属于1380个属,5230个种。
其中细菌2.9万株,酵母1000余株,丝状真菌1000余株,古菌57株以及噬菌体6株。MCCC海洋菌种资源种类新颖多样,应用潜力巨大。
而从分离的海域看,已经涵盖了国内海洋微生物的所有的分离海域和生境,除了我国各近海,还包括三大洋及南北极。
该库有较多的嗜盐菌、嗜冷菌、活性物质产生菌、重金属抗性菌、污染物降解菌、模式弧菌、光合细菌、海洋放线菌、海洋酵母以及海洋丝状真菌等。出于实际应用出发,各地也开始建立起了特色的菌种库资源,目前已经有多个具有自主知识产权的专利菌种成功转化,将为生物制造提供最坚实的基础。广东省微生物菌种保藏中心(GDMCC):是华南地区最大的菌种保藏中心,保藏微生物菌种近4万株,覆盖环境、工业、农业、分析、食品、药用真菌行业各类生产和科研教学用微生物。食品微生物专用菌种库:由云南省农业科学院牵头建立,目前已保藏菌株10600份,涵盖11个目、17个科、43个属、128个种。江南大学:建立了全国最大的益生菌专利菌种库,共收集了2.5万多株菌种,有专利及申请专利的益生菌有200株,覆盖了可用于食品的菌种目录上的所有菌种。
云南农业大学:建成我国首个咖啡发酵专用微生物菌种资源库安琪生物:安琪建立了全国最系统的工业酵母菌种资源库之一。其中,酵母菌达2000余株,保藏各类特色菌种4300余株,涵盖了380余个种属,备份6万余份。慕恩生物:聚焦于生物农业,拥有超30万菌株的菌种资源库,是全球最大的商业化微生物菌种保藏中心之一。华北制药:创建了国内医药行业最大的菌种资源库,拥有3000多株现代工业发酵生产价值菌种。我国微生物菌种库建设较晚,与之相比海外已经建立起成熟的菌株保藏体系,满足了各项工业及科研应用,不过缺点是价格非常高。美国典型菌种保藏中心(ATCC):成立于1925年,是世界上最大最权威的微生物资源中心,目前能够提供近3万种动植物细胞、标准品和菌株。德国微生物菌种保藏中心(DSMZ):成立于1969年,号称拥有世界上最全面的生物资源中心,专注于细菌、真菌、质粒、抗菌素、人体和动物细胞、植物病毒等各类微生物的分类,总计超过89000种物质。
日本微生物菌种保藏中心(JCM):是日本最大的国家级微生物菌种保藏机构,拥有细菌、放线菌、古菌、酵母、真菌、藻类、噬菌体和DNA等资源。英国典型培养物保藏中心(NCTC):成立于1920年,是世界上最早建立的菌种保藏中心之一,提供 5500 多种类型和参考细菌菌株。